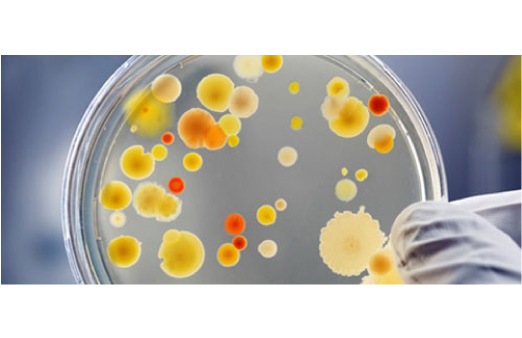
Xu hướng #6: Công nghệ vi sinh và cảm biến mùi – thế hệ tẩy rửa thông minh

1. Mở đầu: Khi “sạch” không còn chỉ là bọt trắng
Thế giới đang thay đổi, và khái niệm “sạch” cũng không còn giống như 10 năm trước.
Nếu như trước đây, người ta tin rằng bọt càng nhiều – càng sạch, mùi càng mạnh – càng thơm, thì nay, xu hướng sống xanh và bảo vệ sức khỏe đã khiến chúng ta đặt câu hỏi ngược lại:
“Thứ bọt trắng ấy đến từ đâu? Và nó có thật sự an toàn với da tay, hơi thở, hay dòng nước dưới chân mình không?”
Nước tẩy rửa thiên nhiên đang dần trở thành xu hướng tất yếu của thời đại.
Không chỉ vì yếu tố “xanh” hay “thân thiện môi trường”, mà còn bởi sự an toàn, hiệu quả và tính bền vững mà nó mang lại.
Năm 2025 đánh dấu bước ngoặt lớn của ngành hóa mỹ phẩm – khi người tiêu dùng ngày càng ưu tiên những sản phẩm có nguồn gốc thực vật, enzyme sinh học, và bao bì tái chế.
Tại Ecocare, chúng tôi tin rằng:
“Một giọt sạch lành có thể thay đổi cả hành tinh – nếu nó đến từ thiên nhiên.”
Hãy cùng Ecocare khám phá 6 xu hướng nước tẩy rửa thiên nhiên nổi bật năm 2025, để hiểu vì sao đây không chỉ là lựa chọn, mà là cuộc cách mạng thầm lặng trong từng căn bếp Việt, từng dòng sông, và từng nhịp thở của Trái đất.
2. Xu hướng #1: Enzyme sinh học – sức mạnh làm sạch tự nhiên từ bồ hòn

Nếu có một xu hướng đứng đầu năm 2025, đó chính là enzyme sinh học.
Đây là những hợp chất có khả năng phân hủy dầu mỡ, bụi bẩn, vi khuẩn bằng cơ chế sinh học tự nhiên – thay vì dùng hóa chất mạnh như sulfate hay chlorine.
Các loại enzyme thường được chiết xuất từ bồ hòn, rau củ, giúp làm sạch nhẹ nhàng mà vẫn hiệu quả.
Khác với chất tẩy tổng hợp, enzyme không phá hủy bề mặt da, không gây kích ứng, và đặc biệt thân thiện với nguồn nước – khi thải ra, chúng tự phân hủy sinh học, không gây ô nhiễm.
👉 Đọc thêm:
5 xu hướng ứng dụng enzyme bồ hòn trong sản phẩm chăm sóc gia đình
Tại sao enzyme bồ hòn đang “lên ngôi”?
- Làm sạch hiệu quả mà không cần hóa chất mạnh
- Dịu lành cho da tay, da em bé
- Giữ được hương thơm tự nhiên từ trái cây
- Tự phân hủy trong tự nhiên, không làm tổn hại hệ sinh thái
Đây chính là “trái tim xanh” trong các sản phẩm nước rửa chén, nước lau sàn, hay nước giặt thiên nhiên thế hệ mới của Ecocare.
3. Xu hướng #2: “Zero sulfate – zero hương liệu tổng hợp”

Người tiêu dùng đang dần tỉnh thức trước hậu quả của sulfate (SLS, LAS) – những chất tạo bọt mạnh trong hầu hết sản phẩm tẩy rửa công nghiệp.
Các nghiên cứu chỉ ra: sulfate có thể phá vỡ lớp lipid bảo vệ da, gây khô rát, viêm da, và làm ô nhiễm nguồn nước.
Bởi vậy, năm 2025 chứng kiến làn sóng “zero sulfate” bùng nổ mạnh mẽ.
Thay thế cho sulfate là những hoạt chất có nguồn gốc từ đầu dừa, dầu cọ, bắp, mía, kết hợp với enzyme bồ hòn, giúp làm sạch nhẹ nhàng hơn nhưng vẫn đạt hiệu quả cao.
Bên cạnh đó, xu hướng “zero hương liệu tổng hợp” cũng được ưa chuộng. Người dùng dần nhận ra rằng “mùi thơm lâu” không đồng nghĩa với “an toàn”, mà đôi khi là kết quả của hàng chục hợp chất nhân tạo.
Hương tự nhiên từ tinh dầu chanh, sả, cam, quế, chanh gừng… vừa dễ chịu, vừa có tác dụng kháng khuẩn, thư giãn tinh thần – một điểm cộng lớn cho nước tẩy rửa thiên nhiên hiện đại.
Tham khảo thêm bài viết: 4 Lợi ích nước rửa chén thiên nhiên với da tay nhạy cảm tại đây.
4. Xu hướng #3: Bao bì tái chế – bước tiến nhỏ cho hành tinh lớn 🌍

Một sản phẩm sạch thật sự không thể “xanh” nếu bao bì của nó vẫn là nhựa dùng một lần.
Vì vậy, các thương hiệu tiên phong năm 2025 – trong đó có Ecocare – đang chuyển mình mạnh mẽ sang bao bì tái chế, tái sử dụng.
👉 Tham khảo:
Thông báo thay đổi tem nhãn Ecocare – hướng tới bao bì bền vững.
Việc chuyển sang bao bì tái chế không chỉ là nỗ lực giảm rác thải nhựa, mà còn thể hiện cam kết lâu dài của Ecocare với lối sống xanh, trách nhiệm với môi trường và cộng đồng.
Mỗi chai sản phẩm khi tái sinh thêm một lần, hành tinh lại được thở dễ dàng hơn một chút.Đó không chỉ là hành động xanh – mà còn là trách nhiệm với hành tinh.
5. Xu hướng #4: Chuyên biệt hóa – Mỗi bề mặt cần một giải pháp riêng 🌿

Nếu vài năm trước, người tiêu dùng chuộng các sản phẩm tẩy rửa “đa năng”, thì đến năm 2025, xu hướng lại chuyển mình sang hướng “chuyên biệt hóa”.
Bởi mỗi bề mặt – từ gỗ, kính, inox cho đến vải sợi – đều có cấu trúc và đặc tính riêng, đòi hỏi công thức làm sạch được thiết kế tối ưu, vừa hiệu quả vừa an toàn.
Thay vì “1 chai cho mọi thứ”, người dùng thông minh đang tìm kiếm “1 giải pháp đúng cho từng vấn đề”:
- 🌸 Nước rửa chén thảo dược dịu nhẹ, làm sạch dầu mỡ mà không gây khô rát da tay
- 🍃 Nước lau sàn thiên nhiên kháng khuẩn, không hóa chất lưu hương – an toàn cho trẻ nhỏ và thú cưng
- 🌼 Nước giặt thiên nhiên loại bỏ vết bẩn cứng đầu, khử mùi hôi ẩm, giúp sợi vải mềm mịn mà không gây kích ứng da
Tại Ecocare, triết lý “hiểu đúng để làm sạch đúng” chính là kim chỉ nam trong phát triển sản phẩm.
Mỗi dòng tẩy rửa đều được nghiên cứu chuyên biệt cho từng nhu cầu – từ giặt giũ, vệ sinh nhà cửa đến chăm sóc quần áo trẻ nhỏ – đảm bảo an toàn cho sức khỏe, thân thiện với môi trường và hiệu quả vượt trội nhờ sức mạnh tự nhiên.
Tham khảo thêm bài viết: 5 lí do mẹ lựa chọn nước giặt thiên nhiên cho bé tại đây.
6. Xu hướng #5: Chứng nhận xanh & minh bạch thành phần

Một sản phẩm tẩy rửa thật sự xanh và an toàn không chỉ nằm ở nguyên liệu thiên nhiên mà còn minh bạch từ công thức đến nguồn gốc.
Năm 2025, người tiêu dùng ngày càng thông minh – họ đòi hỏi bằng chứng rõ ràng cho mọi tuyên bố “thiên nhiên”, từ nguyên liệu, quy trình sản xuất đến độ phân hủy sinh học.
Các chứng nhận quốc tế uy tín trở thành “tấm hộ chiếu xanh” để phân biệt sản phẩm thật sự thiên nhiên với hàng “giả xanh”:
- ECOCERT (Pháp): xác nhận sản phẩm chứa thành phần tự nhiên, hữu cơ, không chứa hóa chất độc hại, đạt tiêu chuẩn khắt khe châu Âu.
- EWG Verified: đảm bảo sản phẩm không chứa chất độc hại, an toàn cho da và môi trường.
- TUV-SÜD, Intertek: kiểm định độc lập, chứng nhận khả năng diệt khuẩn, an toàn 100% cho sức khỏe.
Tại Ecocare, chúng tôi cam kết minh bạch tuyệt đối:
- Công khai tỷ lệ thành phần thiên nhiên trên nhãn, từ enzyme bồ hòn, tinh dầu cam – sả – bạc hà đến các thảo dược.
- Giải thích rõ nguồn gốc, xuất xứ và công dụng từng thành phần.
- Khách hàng có thể yên tâm sử dụng, bởi mọi sản phẩm đều trải qua kiểm nghiệm nghiêm ngặt theo tiêu chuẩn quốc tế, từ an toàn da đầu đến phân hủy sinh học hoàn toàn.
7. Xu hướng #6: Công nghệ vi sinh và cảm biến mùi – thế hệ tẩy rửa thông minh
Một xu hướng thú vị năm 2025 là kết hợp enzyme sinh học với công nghệ vi sinh (probiotic cleaning).
Thay vì diệt sạch tất cả vi khuẩn, công nghệ này nuôi dưỡng lợi khuẩn – giúp cân bằng hệ vi sinh trên bề mặt, khử mùi tự nhiên và ngăn vi khuẩn hại tái sinh.
Một số sản phẩm tiên tiến còn tích hợp cảm biến mùi, giúp nhận diện và xử lý mùi hôi hữu cơ bằng cơ chế tự động.
Kết quả: không chỉ sạch tức thì, mà còn giữ sạch lâu hơn.
Đây là bước tiến mới của ngành tẩy rửa – từ “hóa học sạch” sang “sinh học thông minh”.
8. Lợi ích khi chuyển sang nước tẩy rửa thiên nhiên trong năm 2025

Chọn nước tẩy rửa thiên nhiên không chỉ là xu hướng, mà là lựa chọn cho sức khỏe lâu dài:
- 🌱 An toàn cho da tay, da nhạy cảm và trẻ nhỏ
- 🌿 Không để lại tồn dư hóa chất trong quần áo, bát đĩa
- 🌊 Giảm ô nhiễm nguồn nước, thân thiện hệ sinh thái
- 💧 Giữ mùi hương tự nhiên, không ngột ngạt
- 🔄 Tiết kiệm nhựa, giảm rác thải bao bì
- 💚 Góp phần lan tỏa lối sống xanh – sạch – lành
Tham khảo thêm bài viết: Người bị viêm da cơ địa có nên dùng nước rửa tay không tại đây.
9. Ecocare – tiên phong xu hướng tẩy rửa xanh tại Việt Nam
Với hơn 10 năm nghiên cứu ứng dụng enzyme bồ hòn và thảo mộc tự nhiên, Ecocare đã trở thành thương hiệu tiên phong trong lĩnh vực nước tẩy rửa thiên nhiên tại Việt Nam.
Chúng tôi tin rằng:
“Sạch thật sự là sạch từ tâm – sạch cho cơ thể, cho môi trường, và cho tương lai.”
Mỗi sản phẩm Ecocare là kết tinh của:
- Khoa học enzyme sinh học
- Công nghệ chiết xuất thảo mộc tự nhiên
- Triết lý sản xuất bền vững “từ thiên nhiên – về thiên nhiên”
Từ nước rửa chén, nước lau sàn, đến nước giặt – tất cả đều mang một sứ mệnh: bảo vệ sức khỏe người Việt, tái sinh môi trường sống, và nuôi dưỡng lối sống xanh hiện đại.
10. Kết luận: 2025 – Năm của “Sạch lành và Sống xanh”
Thế giới đang tiến về phía trước, và mỗi lựa chọn của chúng ta hôm nay đều là lá phiếu cho tương lai.
Chọn nước tẩy rửa thiên nhiên không chỉ giúp bạn giữ đôi tay mềm mại, căn bếp sạch tinh, mà còn là hành động nhỏ bảo vệ hành tinh xanh.
Một giọt enzyme bồ hòn có thể không thay đổi thế giới,
nhưng nếu hàng triệu người cùng chọn – thế giới chắc chắn sẽ khác.
Liên hệ với Ecocare để tham khảo và đặt hàng nhé!
☎️Hotline đặt hàng, CSKH: 0981.222.166
☎️Hotline đặt hàng, tuyển ctv đại lý: 0987.686.212
📱Shopee: https://shopee.vn/ecocare_vn
📱Tiki: https://tiki.vn/cua-hang/ecocare
📱Lazada: https://www.lazada.vn/shop/ecocare
📱Tiktok: https://vt.tiktok.com/ZMhs8qVPx/?page=TikTokShop

